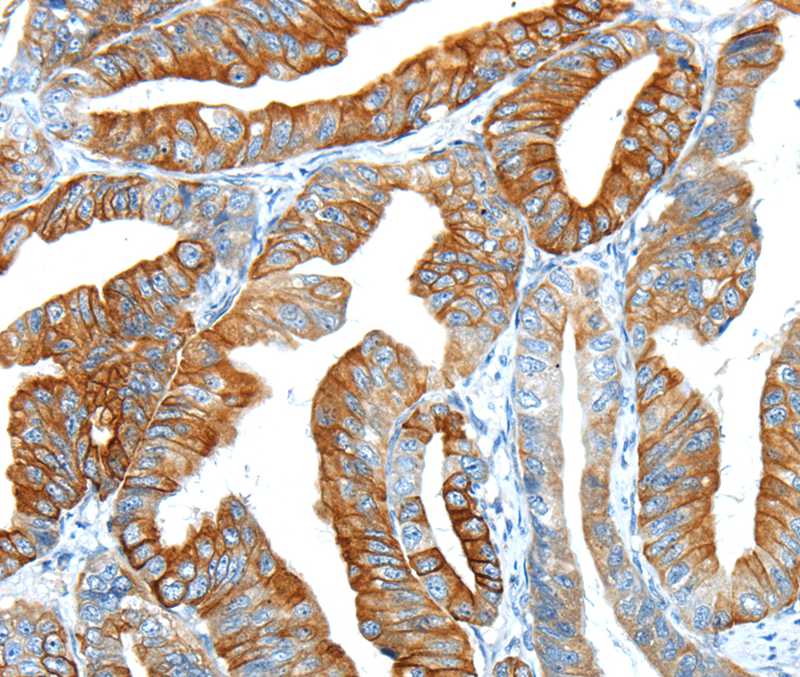

F2 Polyclonal Antibody
CAC08415
ApplicationsImmunoFluorescence, Western Blot, ELISA
Product group Antibodies
TargetF2
Overview
- SupplierBiomatik
- Product NameF2 Antibody
- Delivery Days Customer12
- ApplicationsImmunoFluorescence, Western Blot, ELISA
- Applications SupplierELISA, WB, IF; Recommended dilution: WB:1:2000-1:5000, IF:1:50-1:200
- CertificationResearch Use Only
- ClonalityPolyclonal
- ConjugateUnconjugated
- Gene ID2147
- Target nameF2
- Target descriptioncoagulation factor II, thrombin
- Target synonymsprepro-coagulation factor II; prothrombin; prothrombin B-chain; PT; RPRGL2; THPH1; thrombin factor II
- HostRabbit
- IsotypeIgG
- Protein IDP00734
- Protein NameProthrombin
- Scientific DescriptionThe F2 Polyclonal Antibody (Species: Human) has been validated for the following applications: ELISA, WB, IF.
- Reactivity SupplierHuman
- Storage Instruction-20°C,2°C to 8°C
- UNSPSC12352203